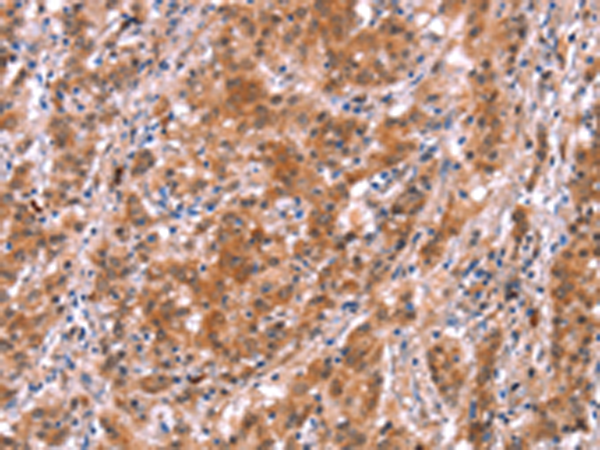

别名:CAS; CAS1; CASS1; CRKAS; P130Cas应用:IHC
反应种属:Human, Mouse, Rat
规格:50μl/100μl
| Description |
|---|
| BCAR1, or CAS, is an Src (MIM 190090) family kinase substrate involved in various cellular events, including migration, survival, transformation, and invasion. The molecular cloning of p130 Cas has shown it to represent a novel SH3 containing signaling molecule with a cluster of multiple putative SH2-binding motifs for v-Crk. By immunoprecipitation analysis, p130 Cas has been shown to be highly phosphorylated at tyrosine residues subsequent to either v-Src p60 or v-Crk-mediated transformation and to form stable complexes with both of these transforming proteins. p130 Cas behaves as an extremely potent substrate for protein tyrosine kinases and has been reported to relocate from the cytoplasm to cell membrane upon tyrosine phosphorylation. One proposed model is that the SH2 domain of v-Crk functions to activate c-Src kinase, which in turn phosphorylates p130 Cas. |
| Specification | |
|---|---|
| Aliases | CAS; CAS1; CASS1; CRKAS; P130Cas |
| Swissprot | P56945 |
| Host/Isotype | Rabbit IgG |
| Storage | Store at 4°C short term. Aliquot and store at -20°C long term. Avoid freeze/thaw cycles. |
| Species Reactivity | Human, Mouse, Rat |
| Immunogen | Synthetic peptide of human BCAR1 |
| Formulation | pH7.4 PBS, 0.05% NaN3, 40% Glycerol |
| Application | |
|---|---|
| IHC | 1/25-1/100 |
| ELISA | 1/1000-1/2000 |
![]() |
The image is immunohistochemistry of paraffin-embedded Human thyroid cancer tissue using P04328(BCAR1 Antibody) at dilution 1/15. (Original magnification: ×200) |
![]() |
The image is immunohistochemistry of paraffin-embedded Human gastric cancer tissue using P04328(BCAR1 Antibody) at dilution 1/15. (Original magnification: ×200) |
本公司的所有产品仅用于科学研究或者工业应用等非医疗目的,不可用于人类或动物的临床诊断或治疗,非药用,非食用。
暂无评论
本公司的所有产品仅用于科学研究或者工业应用等非医疗目的,不可用于人类或动物的临床诊断或治疗,非药用,非食用。
中文

发表回复